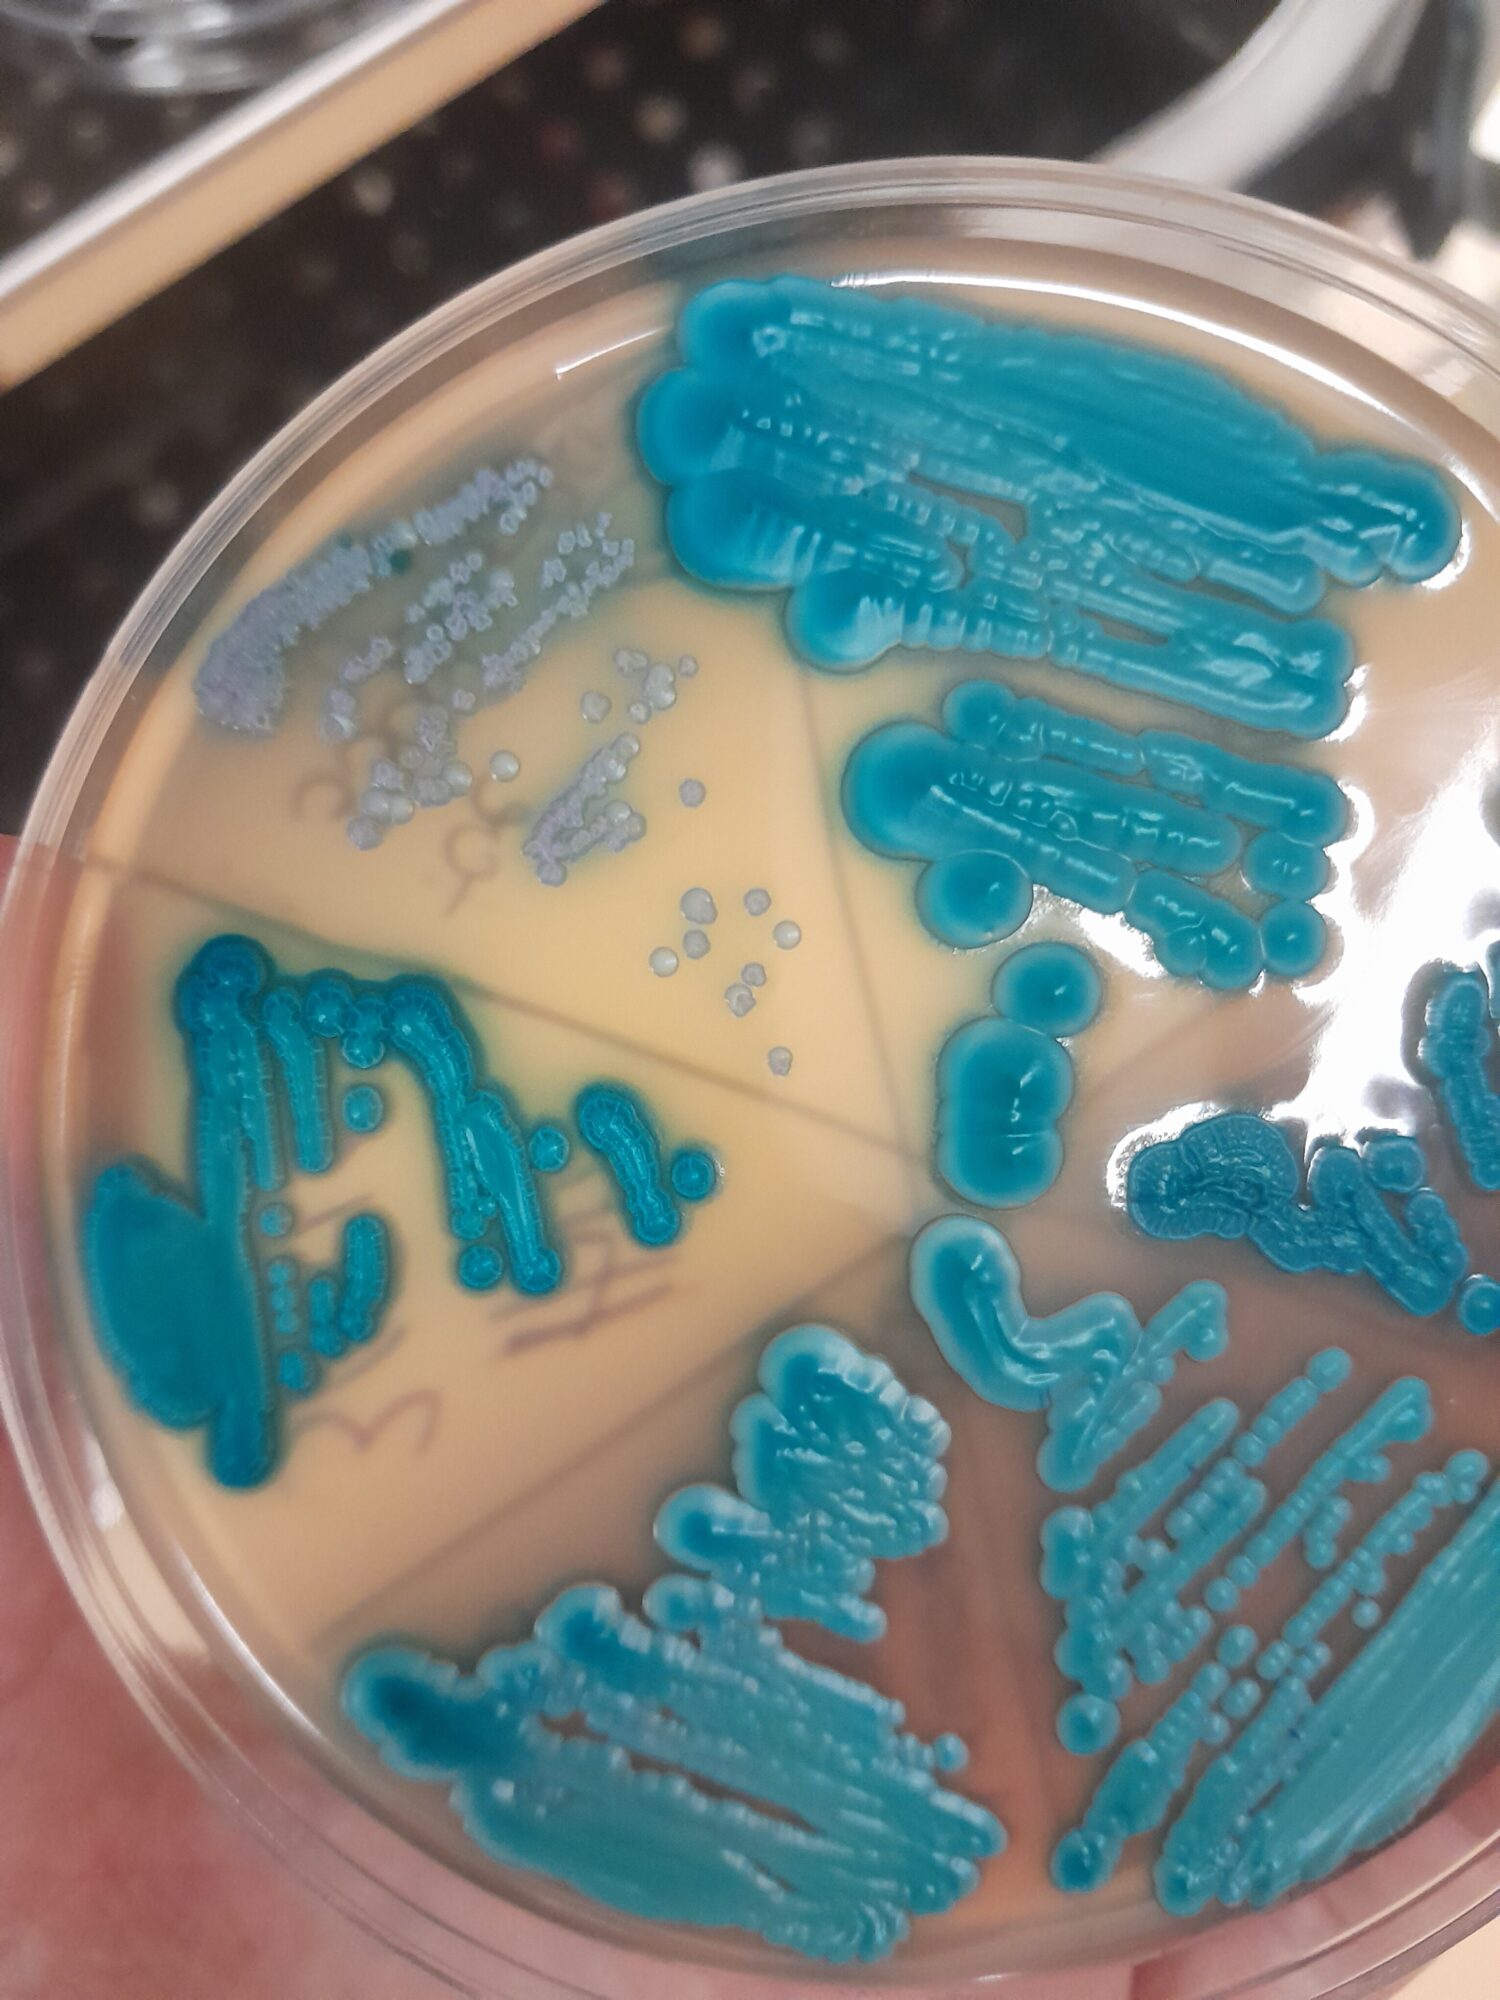

Main content
“One of the biggest threats to global health and development” [1]: That is how the World Health Organisation (WHO) describes antimicrobial resistance (AMR). The numbers are staggering; AMR was directly responsible for 1.27 million global deaths in 2019 and contributed to many more [1]. Making it even more bitter is the fact that some of the main drivers behind AMR are human activity and choices such as the misuse and overuse of antimicrobial drugs.
I am often struck by the fact that, if AMR is such a serious threat, why then does there seem to be such a shroud of indifference surrounding it. Although there are more and more activities to break the silence around AMR, including initiatives such as new research groups and articles written on the topic, I still often experience a certain distance to the topic, especially from clinicians in the Global North. Is this due to the (presumed) availability of last-resort antibiotics or consultant microbiologists to solve the clinical problem? Is it due to it being seen as a far-off global problem, and therefore not a personal cause for concern?
Whatever the reason, I believe that platforms or journals such as Global Health Perspectives
have a responsibility to focus greater attention on this topic. Not only the topic in general, but
also the social and economic interests in halting the AMR threat need to be underlined. Urgent calls to work on health education and to adequately inform the consumer on the proper use of antibiotics need to be strengthened and passed on.
A series of two articles will be published in the coming weeks, presenting a frontline perspective on AMR in Sub-Saharan Africa. The author, Mariska Kreuger, a medical doctor and medical microbiologist, describes her first-hand experience with AMR in Ethiopia and Rwanda. Additionally, as part of the Dutch Global Health Film Festival, the documentary Silent Pandemic was recently screened, followed by a panel discussion [2]. The film focuses on the “strategies and measures used to counter the advance of antibiotic resistance” [3].
The introductory words to the documentary emphasize the need to break the silence now: “The issue is currently so serious that it is being treated with the same degree of urgency on the international policy stage as climate change or migration” [3]. However, as I read these lines, I still wonder. The issue may well be serious, but it feels like the magnitude of the problem is often not felt as such, due to a general lack of public awareness and a lack of interest by the scientific community and policy makers in tackling AMR. Let’s continue with filling that void.
Ryan Proos
Editor Global Health Perspectives